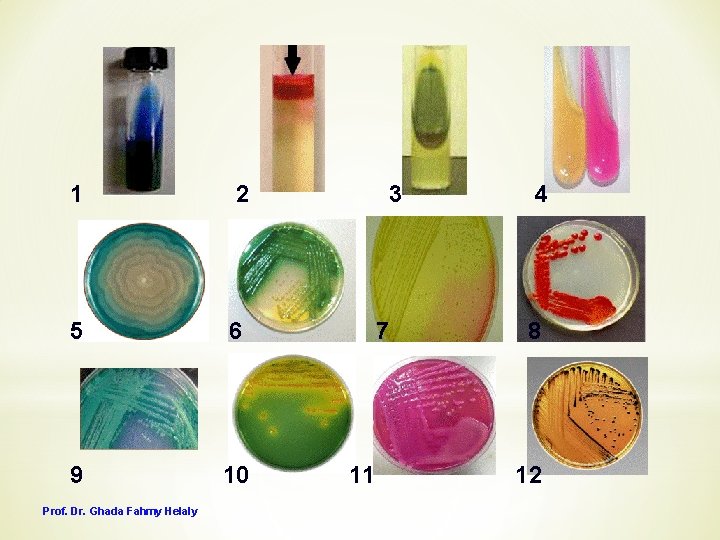
1 2 5 6 9 10 Prof. Dr. Ghada Fahmy Helaly 3 7 11

Biochemical Reactions General Microbiology Lab 5 By Prof

Biochemical Reactions General Microbiology Lab 5 By: Prof. Dr. Ghada Fahmy Helaly

Biochemical tests Tests for Enzymes • Catalase • Oxidase • Urease they are used to identify bacteria used in pseudomonus Test for specific break down products • Methyl Red test • Voges-Proskauer test Test to show ability to utilize a specific substance • Citrate utilization test Prof. Dr. Ghada Fahmy Helaly

Prof. Dr. Ghada Fahmy Helaly Test for metabolism of protein and amino acids Test for metabolism of carbohydrates and related products Combined tests • Indole test • Phenylalanine deaminase test PPA • Sugar fermentation tests • Triple Sugar Iron agar test (TSI) Used to detect more than one thing

Biochemical Tests Enterobacteriaceae The set that we use it to identify the enterobacteriaceae Indole test IMVi. C Reactions Methyl red test Prof. Dr. Ghada Fahmy Helaly Voges. Proskauer test Citrate utilization test

INDOLE TEST Indole Test ❖ To distinguish Enterobacteriaceae based on the ability to produce indole from tryptophan. Principle: � Bacteria that possess the enzyme tryptophanase are capable of hydrolyzing tryptophan with the production of indole, pyruvic acid and ammonia. � Indole production is detected by addition of Kovac’s reagent. A bright pink color on the top layer indicated the presence of indole. positive Media: tryptophan or peptone broth. Pink No color development negative Prof. Dr. Ghada Fahmy Helaly

Interpretation: ❖ Positive: A bright pink color ring at the interface of reagent and broth. ❖ Negative: no color development A B A. Positive – Escherichia coli B. Negative – Klebsiella pneumoniae Prof. Dr. Ghada Fahmy Helaly

Methyl Red / Voges Proskauer (MR/VP) These two tests have many similarities Principle: � Methyl Red test: to determine the ability of bacteria to ferment glucose with the production and stabilization of high acidic end products. Ex: Lactic acid. � Voges Prosakaur: to determine the ability of bacteria to produce non-acidic or neutral end products Ex: acetyl methyl carbinol (acetoin). Prof. Dr. Ghada Fahmy Helaly

Media and Reagents : This is the plane media � Glucose phosphate peptone water (MR-VP medium) � Methyl Red indicator for acid � Voges Proskauer reagents: Barritt's reagents A(5% Alpha-Naphthol, & ethanol), and B (Potassium Hydroxide, & Deionized Water). ** If we have high acid production Methyl red positive+ red color **if its not acidic or neutral Voges Proskauer positive Procedure: � Inoculate 2 glucose broths with inoculating loop. After 48 hours of incubation, add a few drops of MR to one tube, and VP reagents to the other tube. Prof. Dr. Ghada Fahmy Helaly

Results: MR: a + result is red (indicating p. H below 6) and a – result is yellow (indicating no acid production) VP: A + result is red after VP reagents are added (indicating the presence of acetoin) and a – result is no color change. Negative – Klebsiella pneumoniae Positive – Escherichia coli Positive – Klebsiella pneumoniae Negative – Escherichia coli Prof. Dr. Ghada Fahmy Helaly

Citrate utilization test ❖ To determine if a member of the Enterobacteriaceae is capable of utilizing citrate as the sole source of carbon and ammonium as sole nitrogen source. ❖ Media and Reagents: Simmon’s Citrate Agar contains sodium citrate (carbon source), ammonium ion (nitrogen source), & p. H indicator—bromthymol blue. In alkaline media its color is blue / in acidic media is yellow ❖ The alkalinity of the compound following citrate utilization formed raises the p. H of the medium, and the bromthymol blue indicator takes on its alkaline color which is blue. Prof. Dr. Ghada Fahmy Helaly

Interpretation: ❖ Positive: growth with an intense blue color. ❖ Negative: absence of growth and no color change in the medium (remains green). E. Coli -Indole (+) -methyl red (+) -voges proskauer (-) -citrate (-) Positive - Klebsiella pneumoniae Negative - Escherichia coli Prof. Dr. Ghada Fahmy Helaly

Urease test Urease and PPA test - These are specialist to proteus ❖To determine the ability of an organism to produce the enzyme, urease, which hydrolyzes urea. which is in media Principle ❖ Urease splits the urea molecule into ammonia(NH 3), CO 2 and water(H 20). ❖ Ammonia reacts in solution to form an alkaline compound, ammonium carbonate, which results in an increased p. H of the medium and a color change in the indicator to pink red. Prof. Dr. Ghada Fahmy Helaly

Medium: Urea agar Results: A. Positive: Proteus spp. B. Positive: Klebsiella spp. C. Negative: Escherichia coli A B Weak urease Prof. Dr. Ghada Fahmy Helaly C

Phenylalanine deaminase Test • This test determines whether the microbe produces the enzyme phenylalanine deaminase, which is needed to use the amino acid phenylalanine as a carbon and energy source for growth. • The medium used is phenylalanine agar, • Reagents: 10% ferric chloride and 0. 1 N HCl ﻣﺎ ﺍﻟﻪ ﺩﻭﺭ ﻭﻟﻜﻦ ﻟﻦ ﻳﺤﺪﺙ ﺍﻟﺘﻔﺎﻋﻞ ﺍﻻ ﺑﻮﺟﻮﺩﻩ • If phenylalanine deaminase is present, a degradation product is produced from phenylalanine. The product combines with iron compounds in an acidic environment to produce a green color. Ferric chloride + phenylbioveric green color (+) Prof. Dr. Ghada Fahmy Helaly Negative: Escherichia coli Positive: Proteus vulgaris

Sugar fermentation test This test is for many sugars Purpose: Carbohydrate fermentation tests detect the ability of microorganisms to ferment a specific carbohydrate. Media: Sugar media Basic media (peptone +water ) Sugars used : - Glucose- Lactose Maltose - Mannitol - Sucrose Results ▪ p. H indicator: Phenol-Red is red at p. H > 7 ▪ If fermentation occurs, the acidic by-products will change the from red to yellow. ﺳﺒﺐ ﻭﺟﻮﺩﻫﺎ؟ When fermintation happen with acid production + gas - This gas is collected inside these small tubes These small tubes are called Durham tubes

Triple sugar iron agar (3 sugars) In it we can see more than one result in one test tube (many tests in one tube) Principle: • The action of many species of microorganisms on a carbohydrate substrate results in the acidification of the medium with or without gas formation. • Iron salts reacts with H 2 S to produce an insoluble black precipitate (ferrous sulfide). If fermentation occur: -yellow color TSIA – two reaction chamber -if not : Aerobic slant portion -remain in its orange Anaerobic deep portion color • • • 3 sugars : Lactose 1% Inducator: phenole red (makes the Sucrose 1% with “orange red” color ) Lactose 0. 1% very little media Prof. Dr. Ghada Fahmy Helaly

Biochemical reactions: ❖ carbohydrate fermentation: acid production yellow deep – glucose fermented yellow slant – lactose and/ or sucrose fermented gas formation bubble formation cracking or splitting of the agar upward displacement of the agar pulling away of medium from the walls of test tube ❖ H 2 S production: blackening of the butt ( Fe. S – black precipitate) Prof. Dr. Ghada Fahmy Helaly

Specific for psuedomonus slant Slant red, the lactose is non fermented Pat or deep Bricking H 2 S producer As salmonella Yellow pat Glucose fermentation only As shagella Glucose & lactose fermentation +gas displacement As E. coli Prof. Dr. Ghada Fahmy Helaly

Analytical Profile Index System (API) Prof. Dr. Ghada Fahmy Helaly

Prof. Dr. Ghada Fahmy Helaly

Prof. Dr. Ghada Fahmy Helaly
1 2 5 6 9 10 Prof. Dr. Ghada Fahmy Helaly 3 7 11 4 8 12

*1 -citrate utilization test positive (Klebsilla pneumoniae) *2 -indole positive ( E. coli ) *3 -PPA *4 - Urease *5 -swarming growth *6+9 – pseudomonus *7 - mannitol salt agar *8 -Sarratia marcens *10 - vibrio cholera ( as on TB) *11 -Mac. Conkey lactose fermentation + (E. coli or Klebsiella) *12 -Salmonella on SS Prof. Dr. Ghada Fahmy Helaly
- Slides: 23